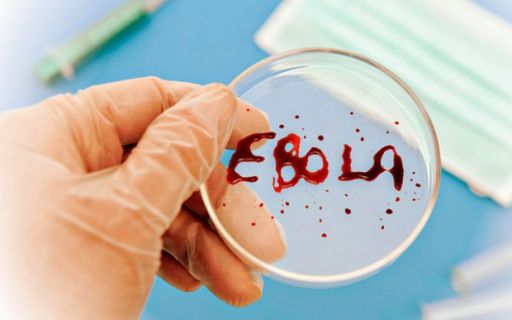

Новости науки и ИТ технологий
Люди жалуются на зависание смартфонов Pixel и Pixel XL
Группа волонтеров сконструировала уникальный квадрокоптер
Официальный сайт операционной системы перестал работать
Суборбитальный космический самолет VSS Unity выполнил свой второй свободный полет
Космическая станция сделала качественный снимок естественного спутника Сатурна
Появилось первое изображение нового смартфона BlackBerry
Шикарное фото ночной Европы демонстрирует Землю из космоса в канун Рождества
Звезда Глизе 710 находится в 64 световых годах от Солнца и приближается к нему
Система искусственного интеллекта умеет готовить завтраки и распознает человеческую речь
Ученые впервые наблюдали рождение облака под микроскопом
Ученые узнали, откуда у человека появился мозг
Ученые из Университета Западного Онтарио создали фигурку в виде снеговика из трех шарообразных частиц диоксида кремния
Нашли вакцину от лихорадки, которая напугала весь мир
Стали известны самые яркие научные открытия текущего года
Индийский онлайн-ритейлер Snapdeal начал продажу наличных денег
Пользователь Reddit под ником teryakiwok пожаловался на проблемы в работе камеры iPhone 7 Plus
Во Франции построили автотрассу из солнечных батарей
Разработчики из Украины запустили приложение, которое контролирует трату времени
Киберполиция пресекла работу пиратского онлайн-кинотеатра mega-cinema.pp.ua
В новинке от компании Apple нашли критическую неполадку камеры

Продовжуючи перегляд сайту inform-ua.info, ви підтверджуєте, що ознайомилися з
Продовжуючи перегляд сайту inform-ua.info, ви підтверджуєте, що ознайомилися з